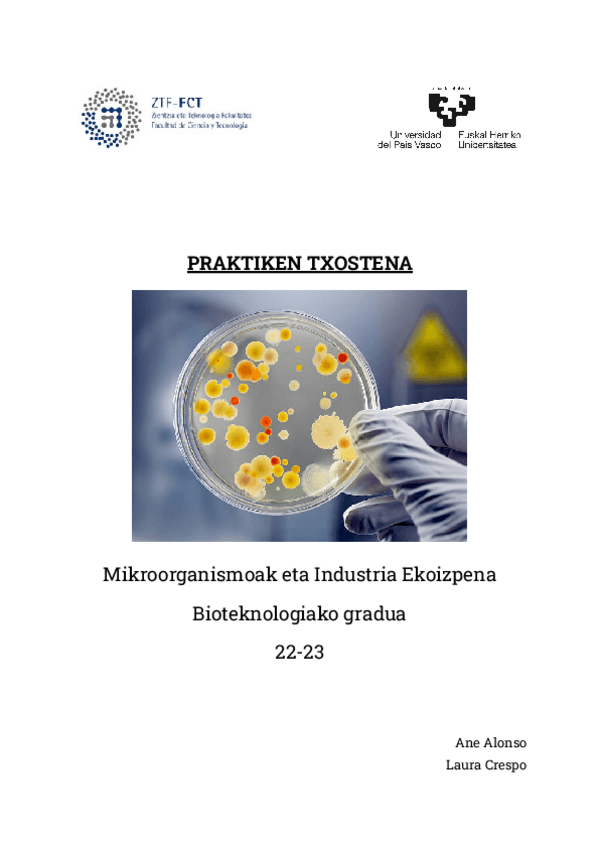

Microorganismos y Producción Industrial
apuntes
-
PREGUNTAS DE EXAMEN
Estas son las preguntas que luego caen en el examen
He publicado nuevos apuntes de 2º Microorganismos y Producción Industrial: 8.-gaia-arkeo-eta-Gram-laburpena.pdf
He publicado nuevos apuntes de 2º Microorganismos y Producción Industrial: 6.-gaia-laburpena.pdf
He publicado nuevos practicas de 2º Microorganismos y Producción Industrial: MIKRO-TXOSTENA.pdf
He publicado nuevos apuntes de 2º Microorganismos y Producción Industrial: industria-laburpenak.pdf
He publicado nuevos apuntes de 2º Microorganismos y Producción Industrial: m.o.-batzuk.pdf
He publicado nuevos apuntes de 2º Microorganismos y Producción Industrial: mikrie-ariketentzat.pdf
ejercicios
-
GALDERAK
He publicado nuevos ejercicios de 2º Microorganismos y Producción Industrial: GALDERAK
He publicado nuevos trabajos de 2º Microorganismos y Producción Industrial: MIKROBIOMIK.pdf
He publicado nuevos practicas de 2º Microorganismos y Producción Industrial: PRAKTIKEN-TXOSTENA-944.pdf
ejercicios
-
MINTEGIA
He publicado nuevos ejercicios de 2º Microorganismos y Producción Industrial: MINTEGIA
apuntes
-
Microorganismos y Producción Industrial
He publicado nuevos apuntes de 2º Microorganismos y Producción Industrial: Microorganismos y Producción Industrial
apuntes
-
Mikroorganismoak eta industria ekoizpena
He publicado nuevos apuntes de 2º Microorganismos y Producción Industrial: Mikroorganismoak eta industria ekoizpena
apuntes
-
Tema 24
He publicado nuevos apuntes de 2º Microorganismos y Producción Industrial: Tema 24

¡Estás al día!
Has visto todos los archivos